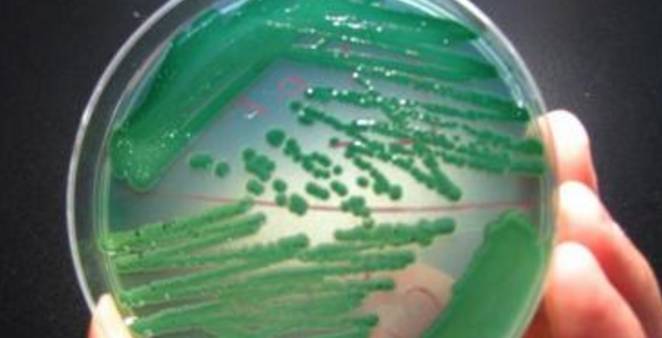

你知道嗎?奠定了歐洲文明基礎的古希臘居然是毀于一場聞所未聞的大瘟疫;羅馬帝國的命運居然也是由大瘟疫而改變;令人難以置信的是,在戰爭之外居然還有另外一場恐怖的大戰-- 瘟疫。
更令人難以置信的是,中國東漢末年三國鼎立局面的形成、基督教的興衰、文藝復興時期的到來、拿破侖命運的轉折,居然也都掌握在一只看不見的黑手 --大瘟疫。了解大瘟疫的發生歷史,我們也許可以找到使人類遠離瘟疫的方法。
那么對于水產養殖朋友們來說,了解弧菌的特點也許能讓我們更好的防御病害的產生。今天讓我們深入的了解這些橫行于水產業的霸主究竟是何面目。
弧菌科介紹
外觀:菌體短小、彎曲成弧形或直桿狀、具有一端單一鞭毛、運動迅速;
革蘭氏染色:革蘭氏染色陰性;
呼吸:兼性厭氧,發酵葡萄糖,大多數菌株氧化酶陽性;
生長需求:許多菌株生長需要2%~3%氯化鈉;
分布:弧菌科細菌廣泛分布于自然界,以水中最為多見,其中有一些種對人類致病。

弧菌科家族成員
常見的弧菌屬有36種,其中致病性弧菌就有12種,其中副溶血弧菌、溶藻弧菌、霍亂弧菌等最為常見。
菌落特征:
在TCBS平板上,呈黃色的菌落有可能是溶藻弧菌、麥氏弧菌或霍亂弧菌等,呈米黃色的有可能是河弧菌,綠色是副溶血弧菌。
在科馬嘉弧菌顯色瓊脂上,粉紫色菌落可能是副溶血弧菌,白色菌落可能是溶藻弧菌,藍色或綠色菌落的可能是霍亂弧菌、創傷弧菌或其他弧菌等。
副溶血弧菌:具有嗜鹽性(halophilic)
對酸敏感,在普通食醋中5分鐘即可殺死;對熱的抵抗力也較弱;對水產養殖動物的危害極大;主要引起食物中毒和急性腹瀉、還可引起傷口感染和菌血癥。
培養特性:
營養要求不高;需氧或兼性厭氧;在無鹽培養基上不能生長,最適合生長的氯化鈉濃度為3.5%,超過8%不能生長;最適pH為7.7~8.0,但pH9.5時仍能生長,最適生長溫度為30~37℃。
抵抗力:
抵抗力弱;不耐熱,90℃ 1min即被殺死;淡水中不超過2日,但海水中能存活47天以上;耐堿怕酸,1%醋酸或50%食醋中1min死亡。本菌對常用消毒劑抵抗力很弱,可被低濃度的酚和煤酚皂溶液殺滅。
副溶血弧菌分布極廣,主要分布在海水和水產品中,我國華東地區沿岸的海水的副溶血性弧菌檢出率為47.5%~66.5%,海產魚蝦的平均帶菌率為45.6%~48.7%,夏季可高達90%以上。除了海產品以外,畜禽肉、咸菜、咸蛋、淡水魚等都發現有副溶血性弧菌的存在。

創傷弧菌和燦爛弧菌
創傷弧菌(海洋弧菌)、燦爛弧菌,兩種弧菌是海水養殖魚類危害較大的弧菌。目前報道的主要是危害黃姑魚、卵形、鯧鲹、大菱鲆、石鰈、鰻鱺和軍曹魚等 。
溶藻弧菌
1、是弧菌屬細菌中耐鹽性最強的致病菌,為嗜鹽性弧菌之一,耐鹽30-100g/L。
2、是一種常見的海洋伺機性病原體,是引起人類、水生動物細菌性疾病的重要病原之一。其數量居海水類弧菌之首。
3、它也是魚、蝦、貝等海水養殖動物的一種條件致病菌,當環境惡化時機體免疫機能下降,溶藻弧菌病容易爆發,特別當水溫在25~32 ℃下容易流行,因此養殖動物的溶藻弧菌病多發生在夏季,爆發時往往會造成水產養殖業巨大經濟損失。
如何鑒別溶藻弧菌
溶藻弧菌會分解TCBS平板中的蔗糖,使其菌落呈黃色,但培養時間超過24h后,部分菌落會變成綠色。

鰻弧菌
鰻弧菌為有鞭毛的革蘭氏陰性細菌,無莢膜,不形成芽孢,能運動,氧化酶陽性。葡萄糖氧化反應呈陽性,具有典型的弧菌屬細菌特征。當水產養殖動物在不良的環境條件下,遭遇不利刺激或是受傷時,會誘發疾病的產生。
鰻弧菌引起的水產養殖動物疾病在世界范圍內流行,可感染鮭魚、虹鱒、鰻鱺、香魚、鱸魚、鱈魚、大菱鲆、牙鲆、黃魚等。鰻弧菌是條件致病菌,當水產養殖動物在不良的環境條件下,遭遇不利刺激或是受傷時,會誘發疾病的產生。
感染鰻弧菌后的魚蝦會表現出病情逐步加深的癥狀,有研究學者報道,部分感染鰻弧菌的魚體表最初出現局部褪色,鰭條、鰭基部及鰓骨下部充血發紅,肛門紅腫,繼而肌肉組織有彌撒性或點狀出血,體表發黑,鰭部出現潰爛;解剖檢驗時有明顯的黃色粘稠腹水,腸粘膜組織腐爛脫落,部分魚肝臟壞死。

哈維氏弧菌
哈維氏弧菌是引起水產動物特別是海水魚類流行性疾病的一種重要病原,曾經在世界范圍內引起海水養殖蝦類疾病 ,也引起海水養殖魚類的流行性疾病爆發。
擬態弧菌
擬態弧菌與不典型的霍亂弧菌關系密切,其形態學、DNA序列及性質與霍亂弧菌極相似,但生化反應不典型, 1981年從腹瀉患者糞便中檢出該菌,故由國外學者命名為'擬態弧菌'。
擬態弧菌系革蘭陰性弧菌,具有單鞭毛,有動力,與副溶血弧菌、霍亂弧菌一樣屬正常海洋菌叢,廣泛存在于自然界河水、海水和海產品中。菌株在不含鈉或僅含1%氯化鈉的營養肉湯中生長良好,可自水生動物中分離出來。

氣單胞菌屬和鄰單胞菌屬
氧化酶陽性,端鞭毛、革蘭陰性桿菌、兼性厭氧。
生態養殖、品質優先
養殖水體中弧菌的危害不言而喻,從根本上來說,是養殖環境生態系統的崩潰造成了弧菌的大爆發,并最終導致養殖動物發病死亡。